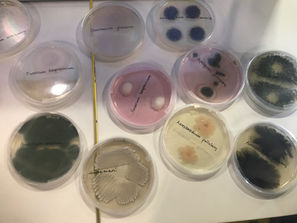

top of page

Sisäilman laatu ja rakennusterveys



Sisäilman laatu ja rakennusterveys
1/6
Palvelut
AeroSmart®–sensori
Sisäilman laadun selvittäminen
Rakennus- ja kosteusteknisillä kuntotutkimuksilla selvitetään ja ratkaistaan kiinteistössä olevan haitan tai altisteen lähde, joka usein ilmenee hajuna tai kiinteistön käyttäjien oireiluna.
Rakennusterveysasiantuntija
-
Sertifioitu rakennusasiantuntija on puolueeton ammattilainen
Kosteus- ja sisäilmatekniset kuntotutkimukset
-
Teemme Valtion asuntorahaston ARA:n hyväksymiä tutkimuksia
-
ARA:n avustusmahdollisuus tutkimuksiin
Sisäilman tutkimukset
Tiiveysmittaukset
Lämpökamerakuvaukset
Toimitilakatsastus
Asbestitutkimus
Tutkimusmenetelmät
Puhtauden- ja pölynhallinta
Olosuhdeseurantapalvelu AeroSmart®
Sisäilmakorjausten valvonta
Kiinteistön kulutusseurantapalvelu
Kosteudenhallintakoordinaattori
Työmaan olosuhdeseuranta
Koulutukset

bottom of page